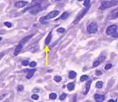
微信截图_20220427153422.png

Agarose bound-SBA;琼脂糖结合大豆凝集素(SBA),Agarose bound Soybean Agglutinin (SBA)
广州pg电子娱乐游戏app
菌物**出示一编的凝集素;另外出示不同荧光标志装饰偶联的凝集素。出示罗丹明、CY3、CY5、FITC、菌物素Biotin、琼脂糖Agarose、DyLight 488、DyLight 594、DyLight 649、Texas Red标志不同凝集素。凝集素(Lectin)就是指属于从各式各样绿植,无脊椎骨绿色和高等教育绿色中分离纯化的糖球球蛋清酶或融入实际糖的球球蛋清酶,而致能凝集红血球(含血型化合物),故名凝集素。使用的为绿植凝集素(Phytoagglutin,PNA),一般因其被导入的绿植命名规则,如刀豆素A(Conconvalina,ConA)、麦胚素(Wheat germ agglutinin,WGA)、芝麻凝集素(Peanut agglutinin,PNA)和黄豆凝集素(Soybean agglutinin,SBA)等,凝集素是同旁内角的总称。凝集素可能身为属于电极来科研神经元膜上特定的的糖基。同每上,凝集素具多价融入实际作用,能与FITC荧光素、生物技术技术素、酶、橡胶悬浊液部分金和铁球球蛋清酶等示踪物融入实际,故而在光镜与/或电镜技术水平体现其融入实际区域。一般使用荧光素、辣根过腐蚀物酶、铁球球蛋清酶、橡胶悬浊液部分金、Cyanine或生物技术技术素等对其对其进行标签。玉米凝集素(Soybean Agglutinin, SBA) 豆类凝集素(Soybean Agglutinin, SBA)由几个的规格同类的亚基組成,分子式量约为120kDa,等电点快要pH6.0.豆类凝集素(Soybean Agglutinin, SBA)对α- or β-N-acetylgalactosamine和半乳糖有融合特异形。豆类凝集素(Soybean Agglutinin, SBA)的1个非常重要要的运用是可以用于从人骨髓中离多系统干癌神经元。凭借豆类凝集素(Soybean Agglutinin, SBA)隔离的癌神经元也不会情况迁移物抗寄主病,故可以用于处理好骨髓迁移中组织机构相匹配性性障碍。
琼脂糖

pg电子娱乐游戏app
微信公众号
官方微信